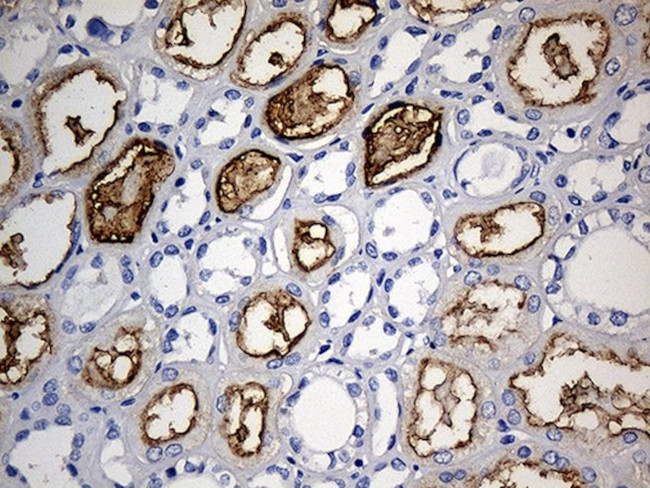
ACE Antibody in Immunohistochemistry (Paraffin) (IHC (P))

Search
OriGene
ACE Monoclonal Antibody (OTI2G5), TrueMAB™
{{$productOrderCtrl.translations['antibody.pdp.commerceCard.promotion.promotions']}}
{{$productOrderCtrl.translations['antibody.pdp.commerceCard.promotion.viewpromo']}}
{{$productOrderCtrl.translations['antibody.pdp.commerceCard.promotion.promocode']}}: {{promo.promoCode}} {{promo.promoTitle}} {{promo.promoDescription}}. {{$productOrderCtrl.translations['antibody.pdp.commerceCard.promotion.learnmore']}}
产品信息
TA812212
种属反应
宿主/亚型
分类
类型
克隆号
抗原
偶联物
形式
浓度
规格
纯化类型
保存液
内含物
保存条件
运输条件
靶标信息
This gene encodes an enzyme involved in catalyzing the conversion of angiotensin I into a physiologically active peptide angiotensin II. Angiotensin II is a potent vasopressor and aldosterone-stimulating peptide that controls blood pressure and fluid-electrolyte balance. This enzyme plays a key role in the renin-angiotensin system. Many studies have associated the presence or absence of a 287 bp Alu repeat element in this gene with the levels of circulating enzyme or cardiovascular pathophysiologies. Two most abundant alternatively spliced variants of this gene encode two isozymes-the somatic form and the testicular form that are equally active. Multiple additional alternatively spliced variants have been identified but their full length nature has not been determined.
仅用于科研。不用于诊断过程。未经明确授权不得转售。
篇参考文献 (0)
生物信息学
蛋白别名: ACE; angiotensin converting enzyme precursor (EC 3.4.15.1); angiotensin I converting enzyme (peptidyl-dipeptidase A) 1; angiotensin I-converting enzyme; angiotensin I-converting enzyme precursor (EC 3.4.15.1); Angiotensin-converting enzyme; carboxycathepsin; CD143; CD143 antigen; dipeptidyl carboxypeptidase 1; Dipeptidyl carboxypeptidase I; Kininase II; MGC26566; peptidase P; unnamed protein product; Zn2+ carboxydipeptidase enzyme which transforms angiotensin I into angiotensin II an active vasoconstrictor protein; splice-site mutation IVS25+1G-->A leads to the retention of intron 25 resulting in a frameshift which leads to a premature stop codon
基因别名: ACE; ACE1; CD143; DCP; DCP1
UniProt ID: (Human) P12821
Entrez Gene ID: (Human) 1636